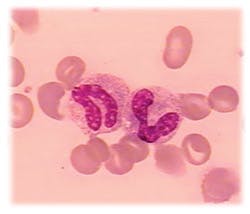
Mlo1103stab Mlo1103stab

An
interesting array of lab queries gets expert attention
Stab cells
Q:
Why are banded neutrophils called stabs?
Schilling developed a reporting format in which increases in the more immature band cells were noted on the report sheet to the left of the segmented neutrophils. If there was an increase in stabs or bands, it was called a left shift.
To Schilling, band neutrophils were the stabkernige (i.e., with stab nuclei), because they looked like a shepherds staff for which the German word is stab. This term has persisted since. Dr. L.W. Diggs reviewed the history of neutrophil counts at the 1977 CAP Aspen Conference on Differential Leukocyte Counting, and his remarks are
informative.1
Since then, flow cytometric methods have increasingly displaced the morphologic differentiation of leukocytes in hematology laboratories. But the classic left shift of transitional neutrophils, as an indicator of acute inflammation or infection, has become somewhat problematic with these instruments. Therefore, there is a growing consensus to merge the immature neutrophils and report them together as immature granulocytes. Now there is a debate on the best way to standardize differentials among these various methodologies in order to provide the best laboratory data, as well as to avoid confusion for the
clinicians.2
John A. Koepke, MD
Professor Emeritus
of Pathology
Duke University Medical Center
Durham, NC
References
- Diggs LW. Highlights in the history of neutrophil counts. In: Differential Leukocyte Counting, JA Koepke, editor. College of American Pathologists. Skokie, IL:1978.
- Koepke JA. How should neutrophil reactions be measured? (editorial) Laboratory Hematology. 1995;1: 87-88.
Freezer standards
Freezer
standards
Q: I am trying to find a reference
that gives official temperature ranges for refrigerators and freezers. Is there a CLIA standard? Our freezers are typically used for frozen specimens. Our reference laboratory did not have an answer.
A:
Our large reference lab has the following criteria for refrigerator and freezer temperatures: Each lab needs to determine the temperature range for particular items such as reagents and specimens. All refrigerators storing these items should have the same range.
For refrigerators, most areas have set the temperature range as 2C to 8C. The freezer in use in specimen processing for storage is set with a range of -15C to -25C. For some freezers, there will be a colder limit set, such as -25C, based on the requirements of materials stored in them and on the equipment tolerance (do not run the unit too cold and adversely affect the life of the condenser).
Noncertified measuring devices must be both calibrated annually and before placing into service. Our policy has set the tolerance limits of thermometers as 1C compared to an NIST thermometer, with the exception of thermometers in freezers, which is 2C. CAP requires evidence of temperature control and that noncertified thermometers are checked against a standard device.
Neither CLIA nor CAP lists specific temperature requirements for refrigerators or freezers; CLIA does require the laboratory to follow the manufacturers instructions for performing tests, according to all of the instructions in the reagents package inserts. Usually, the insert will give storage conditions for the product, including a temperature range. This then becomes the CLIA-mandated temperature range for the refrigerator or freezer.
CLIA and CAP have no recommended storage requirements for refrigerated or frozen specimens. NCCLS Approved Guideline H 21-A3 says, 6.2 Storage The allowable time interval between obtaining the specimen and testing of the sample will depend on the temperature maintained during transport and storage of sample: 22C to 24C = 2 hours; 2C to 4C = 4 hours; -20C = two weeks; -70C = six months (rapidly frozen).
Cecelia Wright, MT(ASCP)
Bea Layton, MT(ASCP)
Michelle Fisher, MT(ASCP)
ARUP Laboratories
Salt Lake City, UT
Using Cary-Blair medium
with enteric pathogens
Q:
There is often a delay in processing fecal specimens for enteric pathogens. Will the use of Cary-Blair transport medium preserve the viability of the enteric pathogens during transport to the laboratory?
A:
The recovery of intestinal
bacterial pathogens from fecal specimens is influenced by a number of factors. First, most pathogens are susceptible to desiccation, and it is important that the specimen does not dry. Second, low numbers of the organism in the stool will influence recovery. In addition, Vibrio spp require at least 0.5% NaCl in the medium, Campylobacter spp may require a lower oxidation-reduction potential in the medium, and Salmonella and Shigella spp may not survive the change in pH that occurs in unbuffered stool as the temperature drops.1,2,3 It is difficult to design the optimal transport medium for stool pathogens because of the unique requirements demonstrated by the many enteric pathogens.
Cary-Blair transport medium was formulated in 1964, specifically to enhance the viability of Salmonella and Shigella spp during transport to the laboratory. The medium is buffered to prevent shifts in the pH, has a low nutrient content to inhibit the growth of other bacterial species, and contains adequate NaCl and sodium thioglycollate (a reducing agent). A modified version reduces the agar content from 0.5% to 0.16% to enhance the viability of Campylobacter spp. Cary-Blair is recommended as a transport medium for the common intestinal bacterial pathogens.
There are not many recent studies evaluating the recovery of enteric pathogens from delayed transport of fecal specimens in Cary-Blair medium. The data suggest, however, that most Salmonella spp, Shigella spp, Vibrio spp, Yersinia spp and Campylobacter spp are recovered from Cary-Blair held at room temperature for 24 hours, but this may vary with the media produced by different manufacturers.2 In fact, with the exception of Campylobacter spp, the other bacterial species could be recovered after 96 hours at room temperature.2,3 For optimal recovery of Campylobacter spp, the specimen in Cary-Blair transport medium should be kept at 4oC.1
David Sewell, PhD, ABMM
Director of Microbiology
Veterans Affairs Medical Center
Portland, OR
References
- Gilligan PH, Janda JM, Karmali MA, Miller JM, Nolte FS. Laboratory diagnosis of bacterial diarrhea. Cumitech 12A. American Society for Microbiology; Washington, DC:1992.
- Mundy LS, Shanholtzer CJ, Willard KE, Peterson LR. An evaluation of three commercial fecal transport systems for the recovery of enteric pathogens. Am J Clin Pathol. 1991:96:364-367.
- Wasfy M, Oyofo B, Elgindy A, Churilla A. Comparison of preservation media for storage of stool samples. J Clin Microbiol. 1995:33:2176-2178.
MLO’s Tips from the Clinical Experts department provides
practical, up-to-date solutions to readers’ technical and clinical
issues from a panel of experts in various fields. Readers may send
questions to Dan Baer by fax, (503) 636-7932; or e-mail, [email protected].
November 2003: Vol. 35, No. 11
© 2003 Nelson Publishing, Inc. All rights reserved.